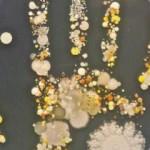
&Ouml;ğrendiğinizde hayrete d&uuml;şeceğiniz ger&ccedil;ekler!

Sıradışı Bilgiler Haberleri
“sıradışı bilgiler” etiketine sahip 50 sonuç bulundu.
DÜNYA
Gerçek olduğuna inanmakta zorlanacağınız fotoğraflar!

DÜNYA
İşte gerçeğini öğrendiğinizde şaşıracağınız bilgiler...

DÜNYA
İnsanlığı hayrete düşüren gerçekler

DÜNYA
Öğrenince çok şaşıracaksınız!

DÜNYA
Dünyanın en ilginç ama gerçek bilgileri

DÜNYA
Meğer bu bilgilerin çoğunu yanlış biliyormuşuz!

DÜNYA
Bu yöntemler hayat kurtarıyor!

GÜNCEL
İlk kez duyacaksınız! Hayvanlar hakkında şaşırtan gerçekler!

DÜNYA
İlginç yer: 'Deve kuşu ayaklı' insanların köyü!
DÜNYA
Öğrendiğinizde hayrete düşeceğiniz gerçekler!

DÜNYA
İlginç ama gerçek! Bunları daha önce hiç duymadınız!

DÜNYA
Gerçek olduğuna inanmakta zorlanacaksınız!

DÜNYA
En ilginç ama gerçek bilgiler! Öğrenince şaşıracaksınız!

GÜNCEL
205 bin liralık lastik eskiyince bakın ne yaptı!

DÜNYA
Dünyayı böyle kandırmışlar! Şaşıracağınız gerçekler...

DÜNYA
İnanması zor ama bir o kadar da gerçek fotoğraflar!

DÜNYA
Öğrendiğinizde şaşıracağınız birbirinden ilginç şaşırtıcı gerçekler

DÜNYA
Pet şişeden bunu yapmak kimsenin aklına gelmezdi!

DÜNYA
Çok ilginç yaşamlarıyla Raute kabilesi

YAŞAM
Mavi yumurtlayan tavuk görenleri şaşırtıyor

DÜNYA
Toprağın altına daldı ve...

DÜNYA
Dünyadan şaşırtan gerçekler!

GÜNCEL
Dünyanın en ilginç ama gerçek bilgileri

DÜNYA
Birbirinden ilginç şaşırtıcı gerçekler

DÜNYA
Dünyayı şaşırtan balık! 100 yıldan uzun süredir...

DÜNYA
Sıradan bir taş zannetti ama...

DÜNYA
Kurgu mu? Gerçek mi? Şaşıracaksınız...

DÜNYA
Mısır Piramitleri ile ilgili herkesi böyle kandırmışlar...

DÜNYA
Her gün kullanıyoruz! Peki ne işe yarıyorlar hiç düşündünüz mü?

YAŞAM
100 yıl önceki hallerine şaşıracaksınız!

DÜNYA
Uçak yolcularının bilmediği şaşırtıcı bilgiler

DÜNYA
105 bin liralık lastik eskiyince bakın ne yaptı!

DÜNYA
Belki de daha önce duymadığınız birbirinden enteresan bilgiler

MEDYA
Dubai Prensi'nin kıskandıran fotoğrafları

DÜNYA
Pek az kişinin bildiği ilginç bilgiler

YAŞAM
Hayat kurtaran pratik bilgiler

YAŞAM
Yeryüzünde bulunan altının 200 kat fazlası orada saklı!

DÜNYA
Toprağın altına daldı ve...

GÜNCEL
Dünyanın en ilginç ama gerçek bilgileri

DÜNYA
Dünyanın en ilginç ama gerçek bilgileri

DÜNYA
İnsanı hayrete düşüren gerçekler!

DÜNYA
Yeryüzünde bulunan altının 200 kat fazlası orada saklı!

DÜNYA
Az kişinin bildiği ilginç bilgiler!

YAŞAM
Bunları biliyor muydunuz?

DÜNYA
Bunları daha önce duydunuz mu?

DÜNYA
Öğrenince çok şaşıracaksınız!

DÜNYA
İnanılmaz ama gerçek...

DÜNYA
İşte birbirinden ilginç pratik bilgiler

DÜNYA
Pet şişeyi bakın neye dönüştürdü!

DÜNYA
İnanılmaz ama gerçek...